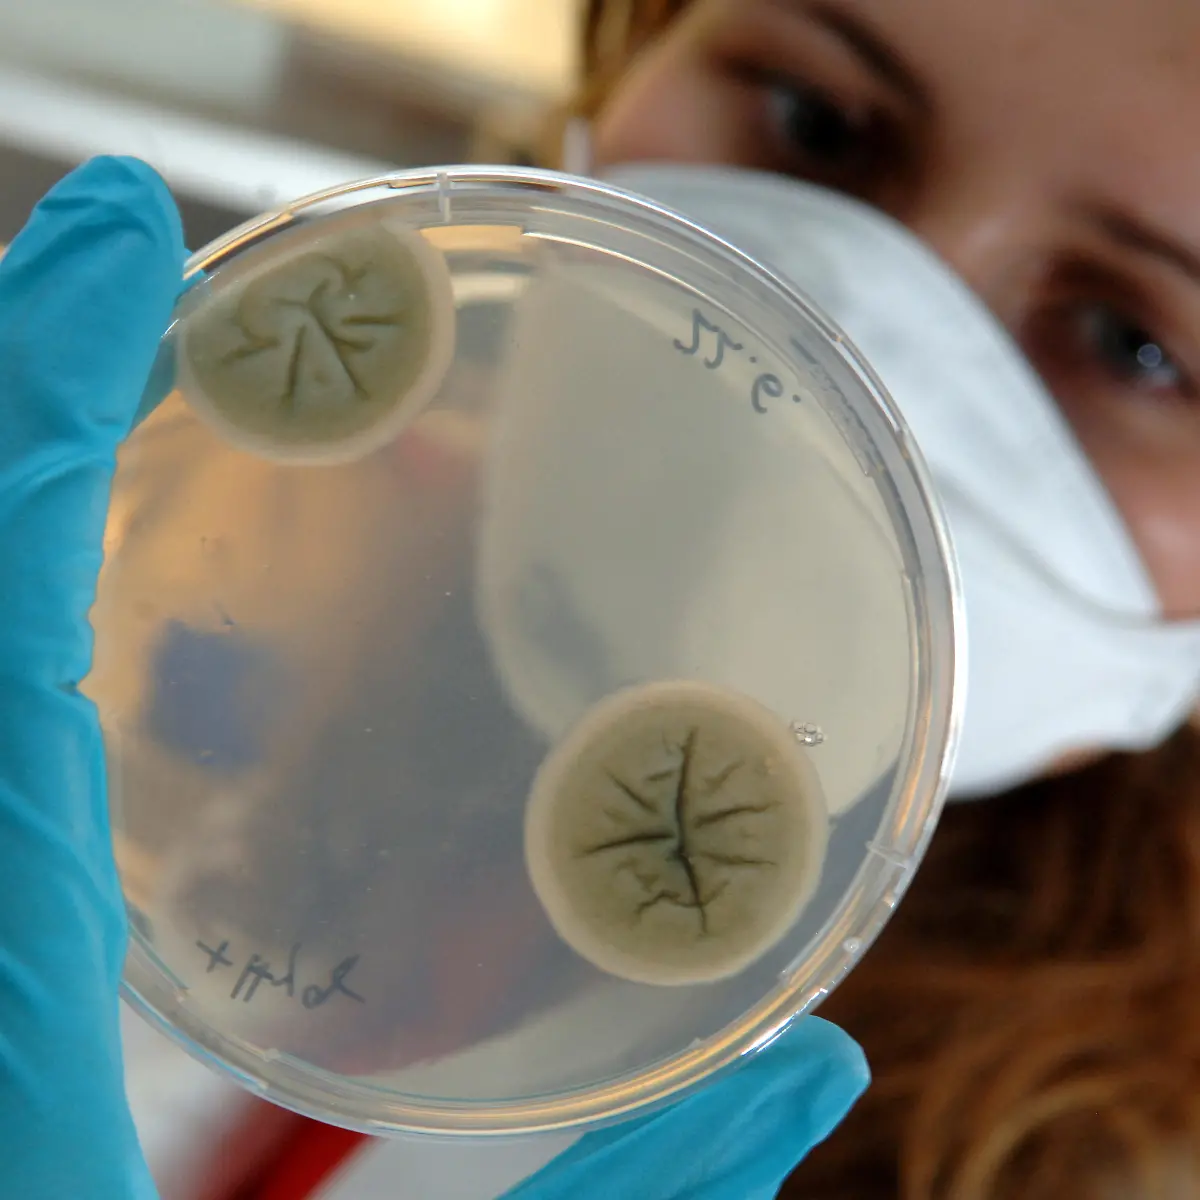
Fluconazol Logo von Fluconazol
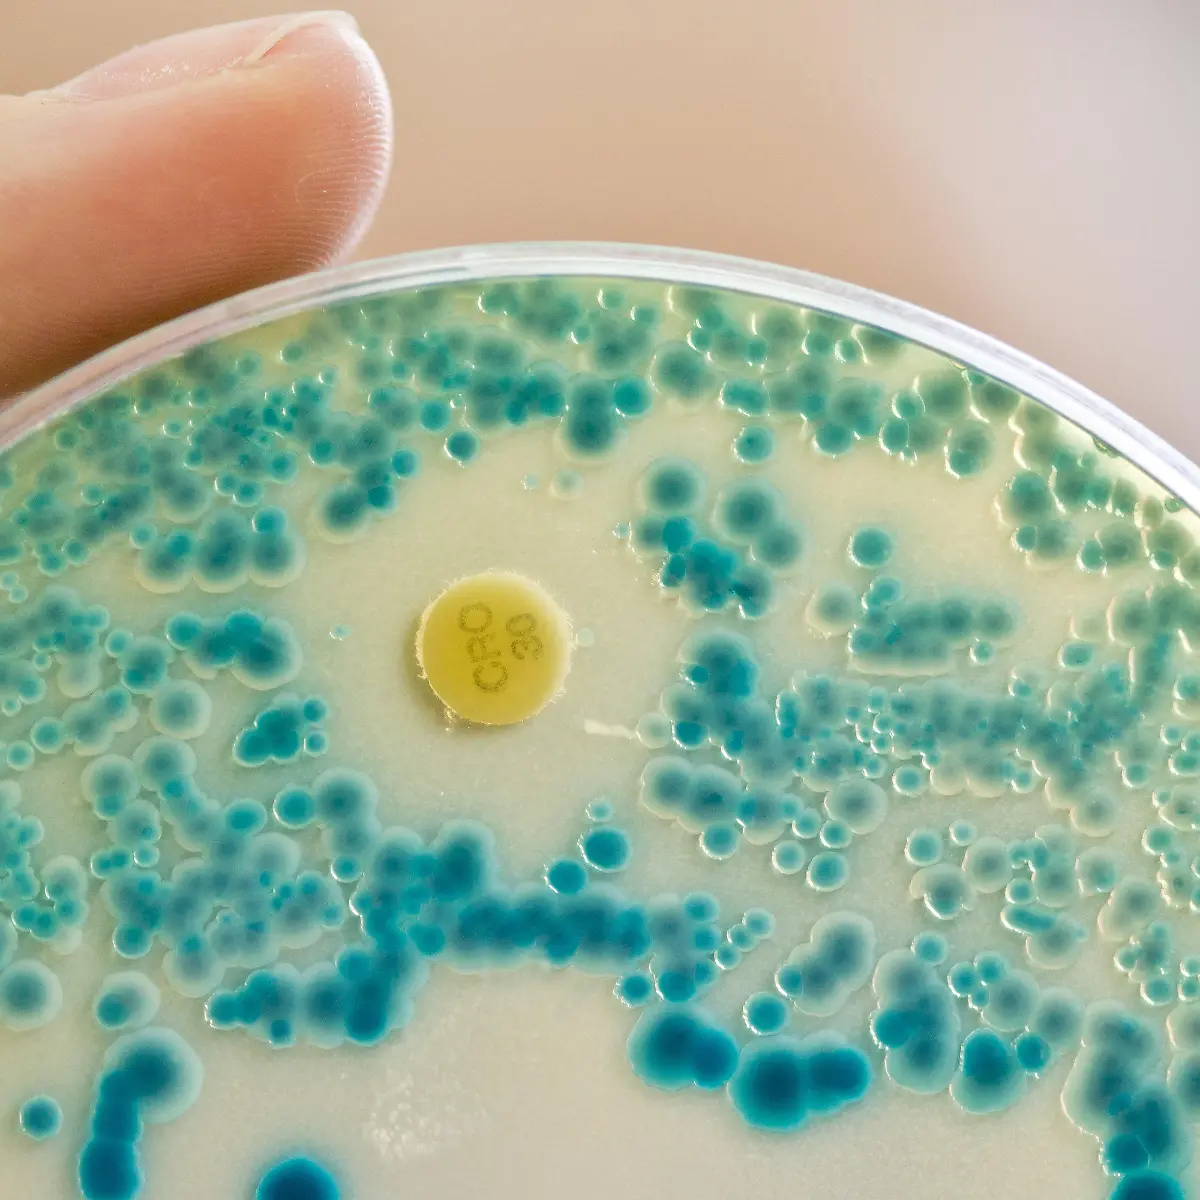
Indikator Logo von Indikator
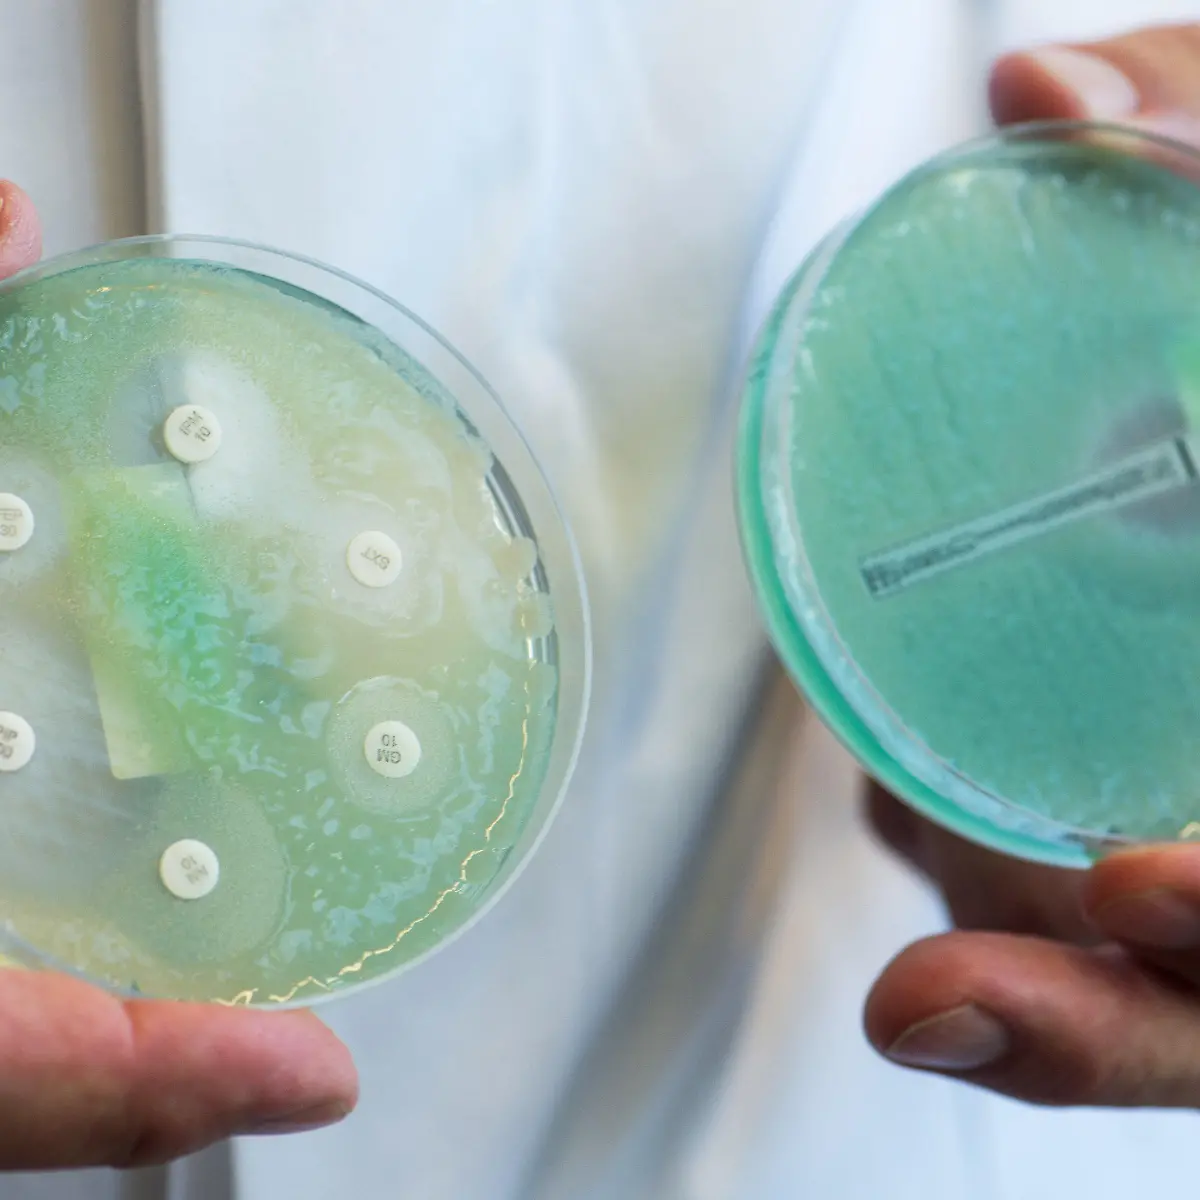
Pseudomonas aeruginosa Logo von Pseudomonas aeruginosa

Gesundheitslexikon – alles Wissenswerte zu eurer Gesundheit

Gesundheitsbegriffe von A bis Z einfach erklärt
Das Gesundheitslexikon von RTL.de bietet euch nützliche Hinweise und beantwortet grundlegende Fragen zu vielfältigen Themen rund um den menschlichen Körper. Hier könnt ihr gezielt nach Informationen suchen. Fachbegriffe – von A wie Arthrose bis Z wie Zöliakie – werden einfach erklärt.
Krankheiten: Was sind Symptome und Ursachen?
Informiert euch über die verschiedenen Krankheiten: Was ihre Ursachen sind, mit welchen Symptomen sie sich üblicherweise bemerkbar machen, welche Behandlungen möglich sind und wie ihr ihnen gegebenenfalls vorbeugen könnt. Die Bandbreite reicht dabei von Volkskrankheiten wie Bluthochdruck, Rückenschmerzen oder Diabetes bis hin zu tropischen Erkrankungen wie Malaria. Auch zu Allergien und Unverträglichkeiten gibt es Einträge. Daneben findet ihr interessante Fakten über die menschlichen Organe in unserem Gesundheitslexikon.
Welche Therapien gibt es und wie laufen sie ab?
Andererseits könnt ihr euch über konkrete Therapieformen und deren Anwendungsbereiche schlaumachen. Wie läuft eine Physiotherapie ab? Welche Risiken und Nebenwirkungen hat eine Chemotherapie? Antworten auf diese und weitere Fragen hält unser Gesundheitslexikon für euch bereit. Gleiches gilt für alternative Heilmethoden wie Osteopathie und Homöopathie. Darüber hinaus findet ihr Wissenswertes über diverse Arten von Bädern, Massagen und weiteren Wellness-Behandlungen.
Wie wirken Medikamente und Heilpflanzen?
Neben Hinweisen zu gängigen Medikamenten bietet das Lexikon Informationen über das Vorkommen und die Verwendung von Heilpflanzen und -kräutern wie Baldrian, Johanniskraut oder Mönchspfeffer. Im Zusammenhang mit einer gesunden Ernährung spielt der Bedarf an Nährstoffen eine wichtige Rolle, um etwa Mangelerscheinungen vorzubeugen. Lest hier nach, wozu der Körper Proteine, Mineralstoffe, Vitamine und Co. braucht und worin diese enthalten sind.
Das kostenlose Gesundheitslexikon gibt Antworten
Das Gesundheitslexikon von RTL.de gibt euch einen Überblick über die verschiedenen Gesundheitsthemen und beantwortet viele grundlegende Fragen, hat jedoch keinen Anspruch auf Vollständigkeit. Bitte bedenkt, dass die Einträge die Beratung durch eine Ärztin, einen Arzt oder in einer Apotheke nicht ersetzen können und nicht zur Selbstdiagnose oder Selbstbehandlung herangezogen werden dürfen. Bei Arzneimitteln solltet ihr zudem stets die beiliegende Gebrauchsinformation sorgfältig lesen und beachten.